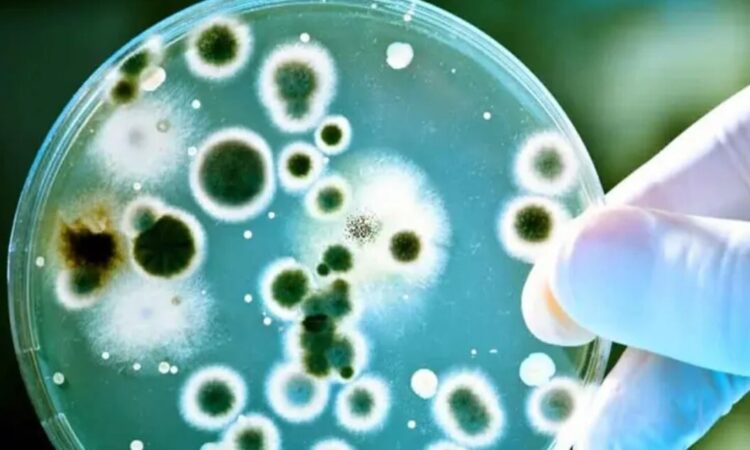

fuente: excelsior
En las profundidades del espacio, donde la vida parece improbable, científicos chinos acaban de hacer un hallazgo fascinante: una bacteria desconocida hasta ahora, que no solo ha sobrevivido, sino que ha desarrollado habilidades sorprendentes en la Estación Espacial China, Tiangong.
Bautizada como Niallia tiangongensis, esta bacteria fue descubierta por los astronautas chinos durante una misión de rutina, en la que simplemente usaron toallitas estériles para frotar superficies del interior de la estación. Luego congelaron las muestras y las enviaron de regreso a la Tierra. Así de simple, pero con resultados extraordinarios.
El análisis posterior, publicado en el International Journal of Systematic and Evolutionary Microbiology, reveló que esta cepa espacial es prima cercana de una bacteria común en la Tierra (Niallia circulans), presente en el suelo, el agua residual, e incluso en nuestros intestinos. Pero aquí viene lo interesante: Niallia tiangongensis muestra mutaciones únicas que podrían ofrecer claves valiosas sobre cómo la vida puede adaptarse y prosperar fuera de la Tierra.
Entre sus habilidades más destacadas está su capacidad para descomponer gelatina como fuente de alimento, algo útil en ambientes donde los nutrientes escasean. Además, presenta diferencias importantes en dos proteínas clave que le permiten resistir el estrés oxidativo, reparar daños por radiación y formar biopelículas habilidades esenciales para sobrevivir en el implacable entorno espacial.
Este descubrimiento forma parte del programa CHAMP (Programa de Microbioma del Área Habitable), que estudia cómo evolucionan y se comportan los microbios durante misiones espaciales prolongadas. Los resultados no solo ayudarán a mejorar la seguridad de futuras misiones tripuladas, sino que también podrían tener aplicaciones en medicina y agricultura en la Tierra.
Curiosamente, no es la primera vez que se descubre una bacteria con “superpoderes” en el espacio. En 2023, astronautas estadounidenses detectaron una variante mutada y resistente a medicamentos de una bacteria común en la Estación Espacial Internacional, un hallazgo que le sha permitido a los científicos conocer que los microorganismos son capaces de evolucionar de formas impredecibles.


